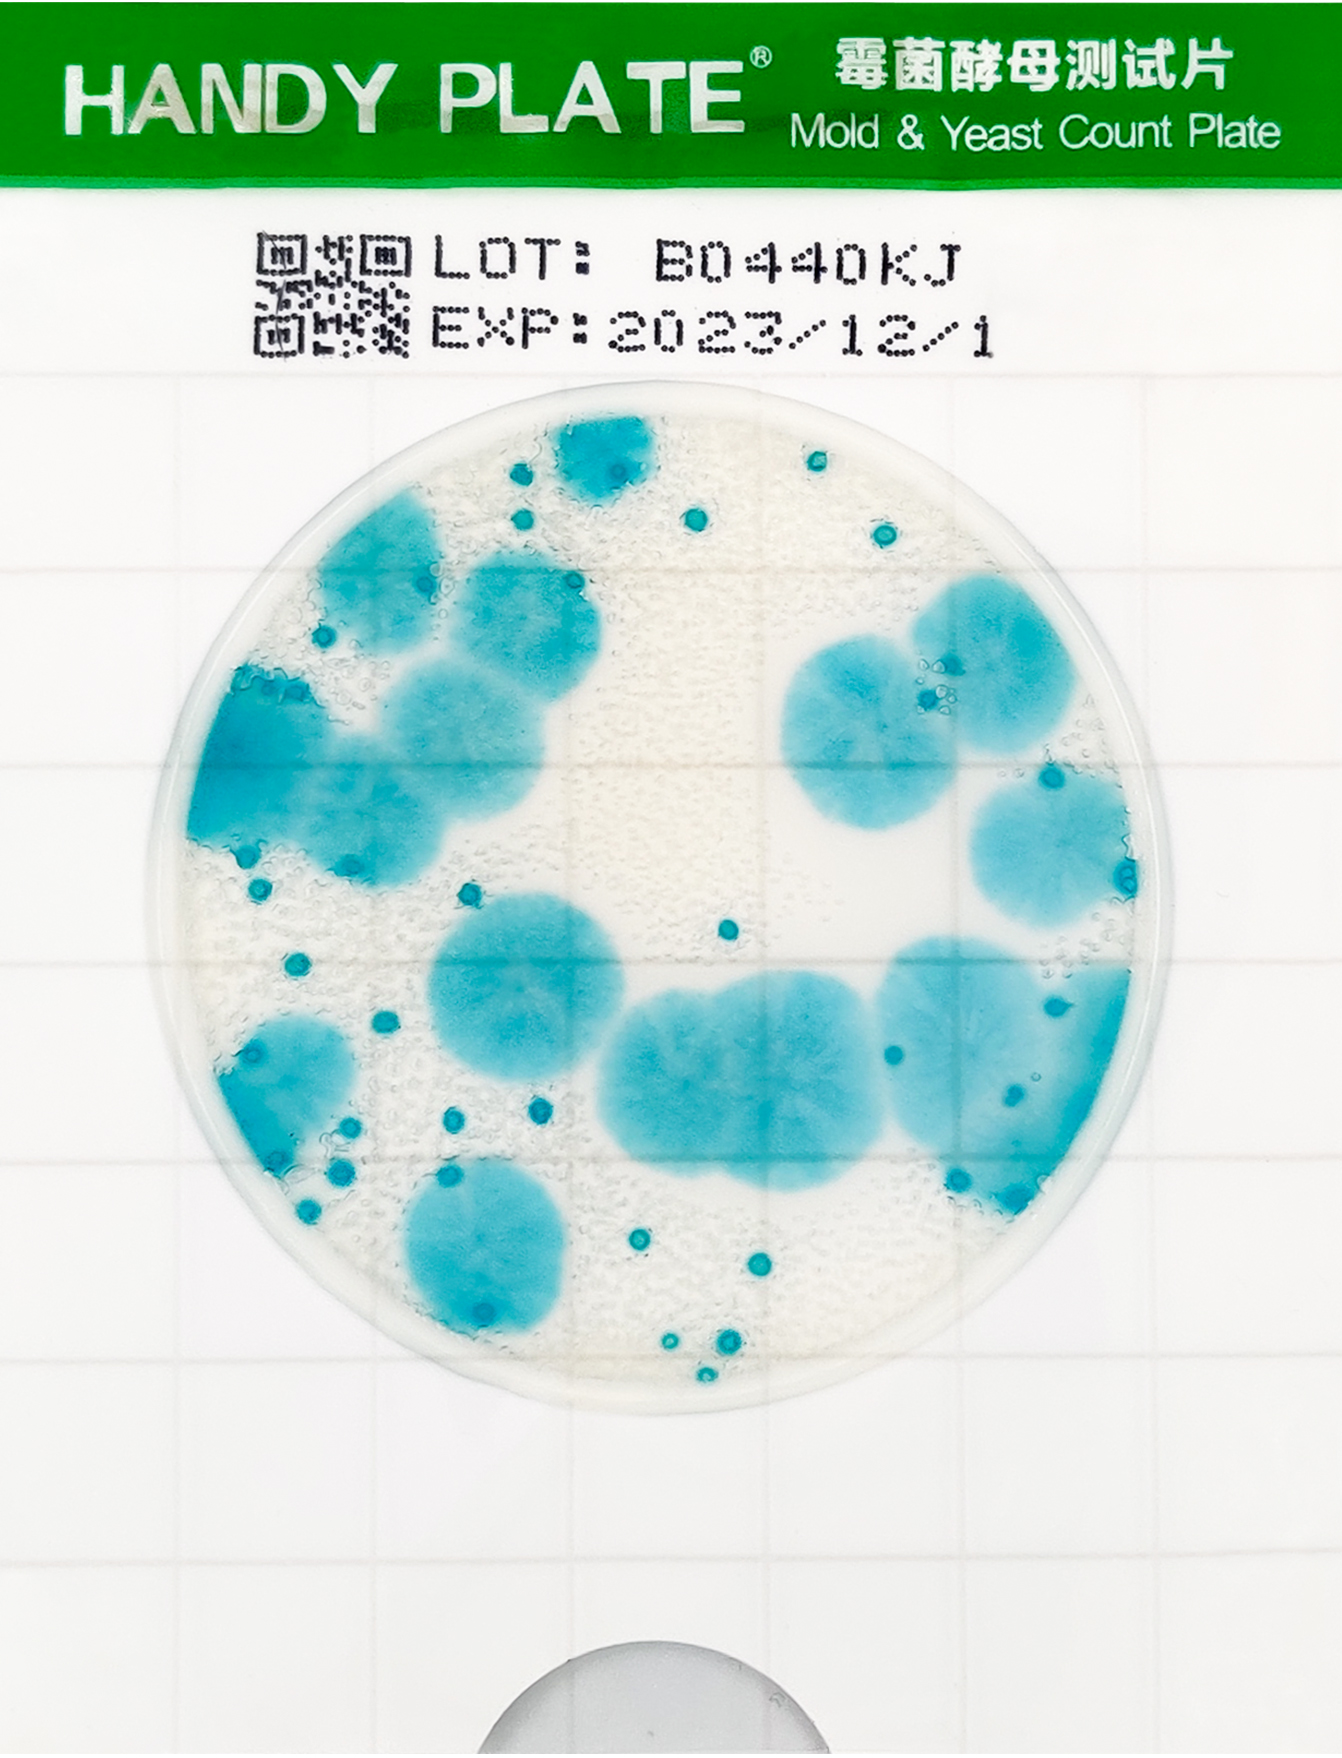
霉菌酵母检测片判读
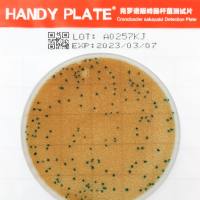
HandyPlate®克罗诺杆菌测试片
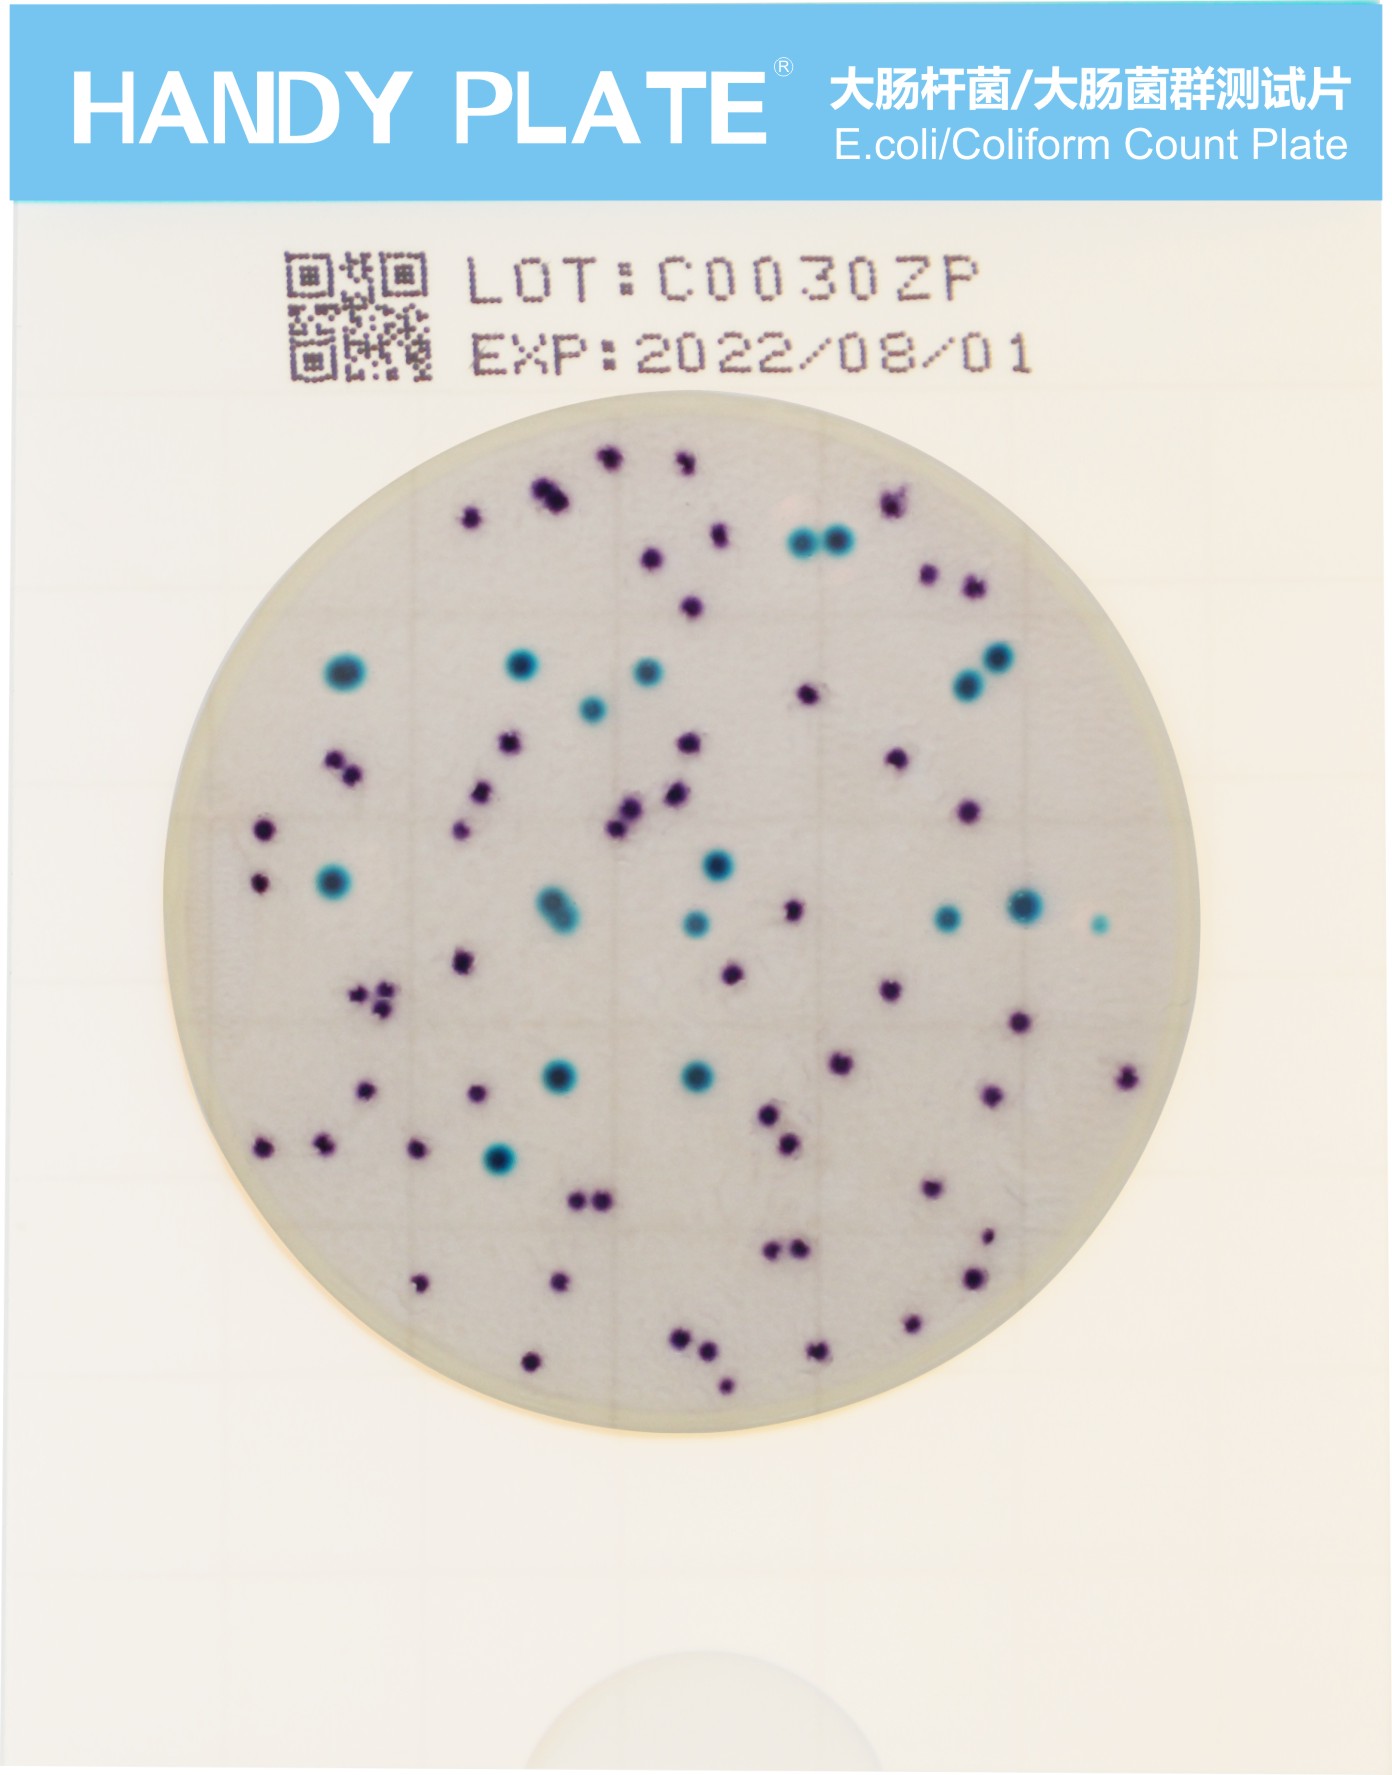
大肠杆菌&大肠菌群测试片
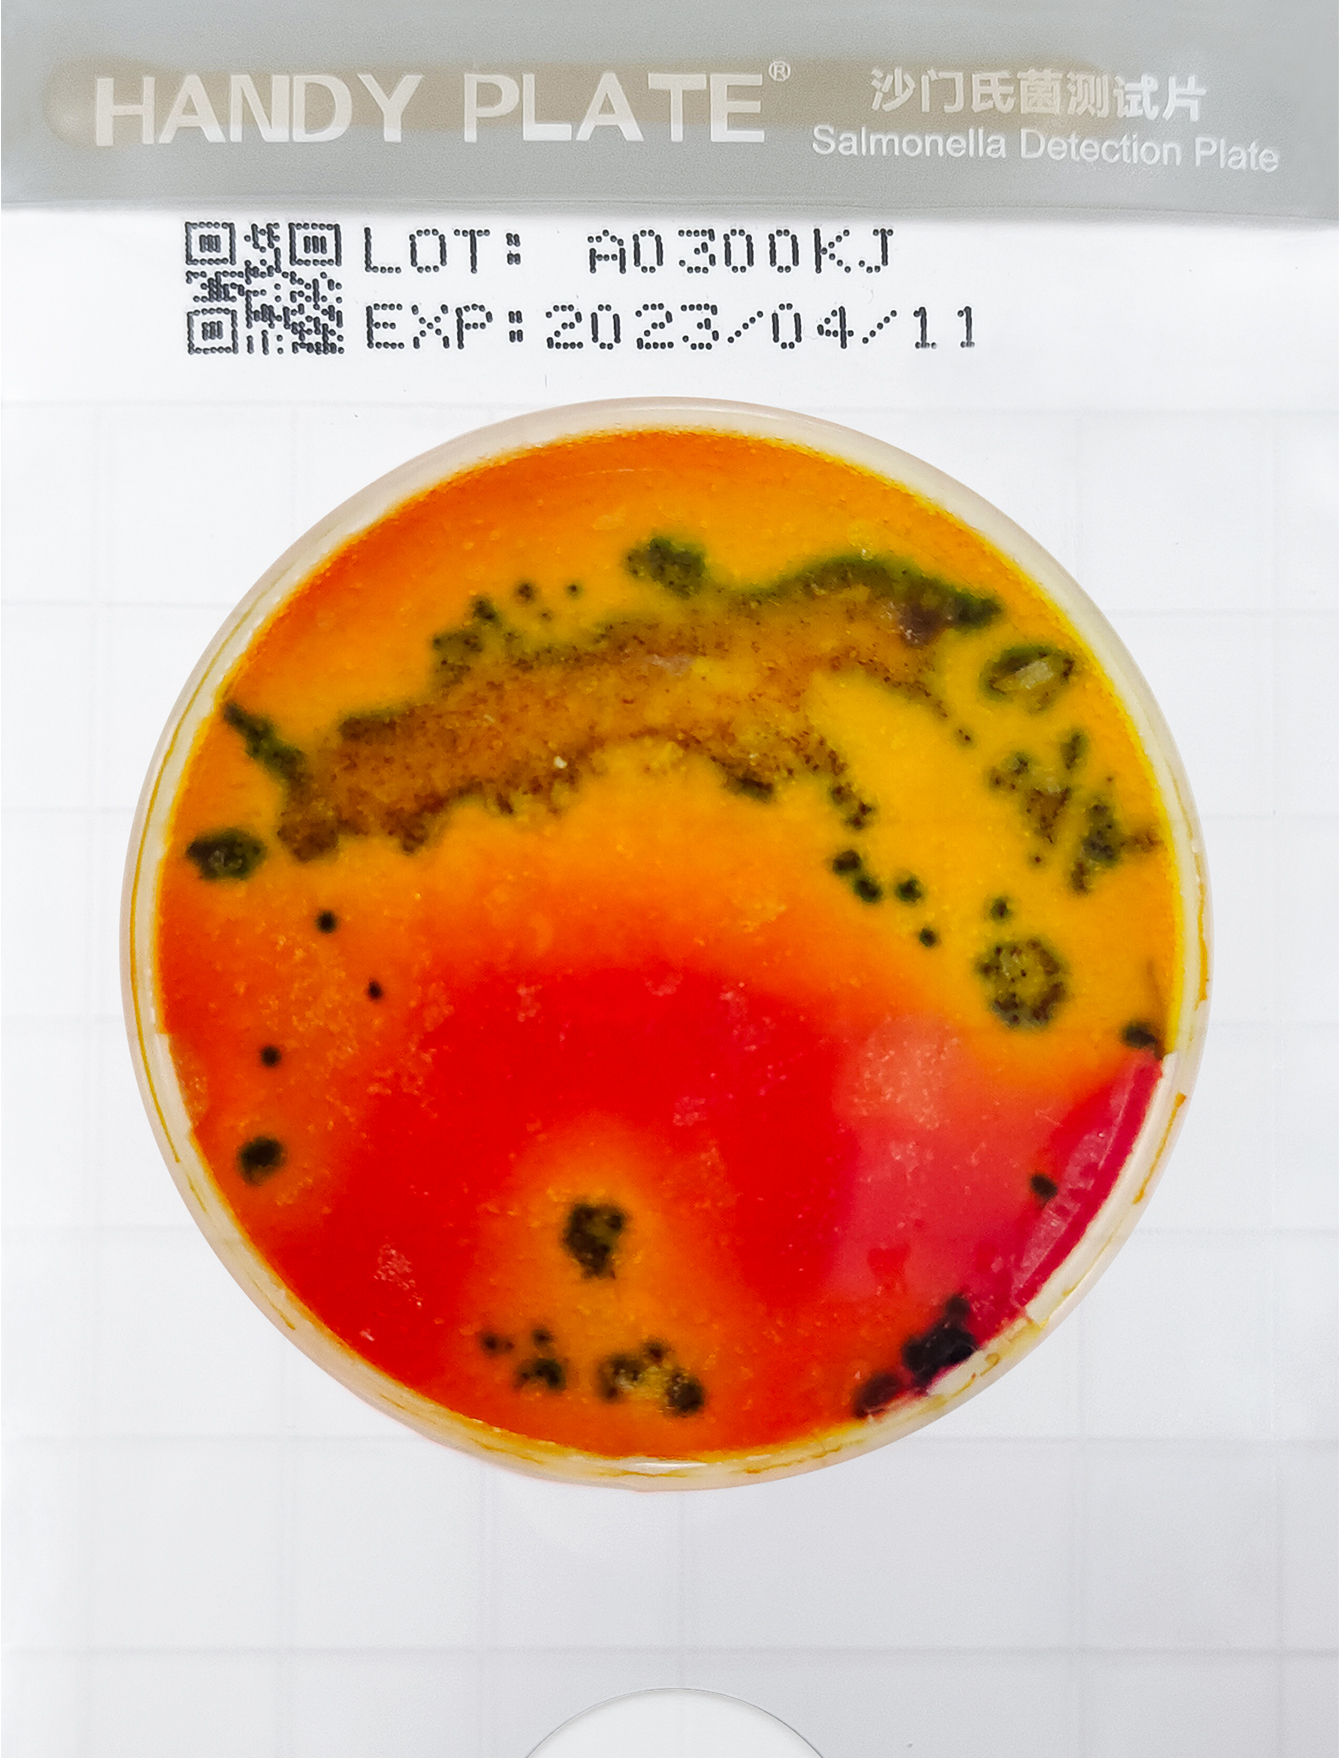
沙⻔⽒菌测试⽚
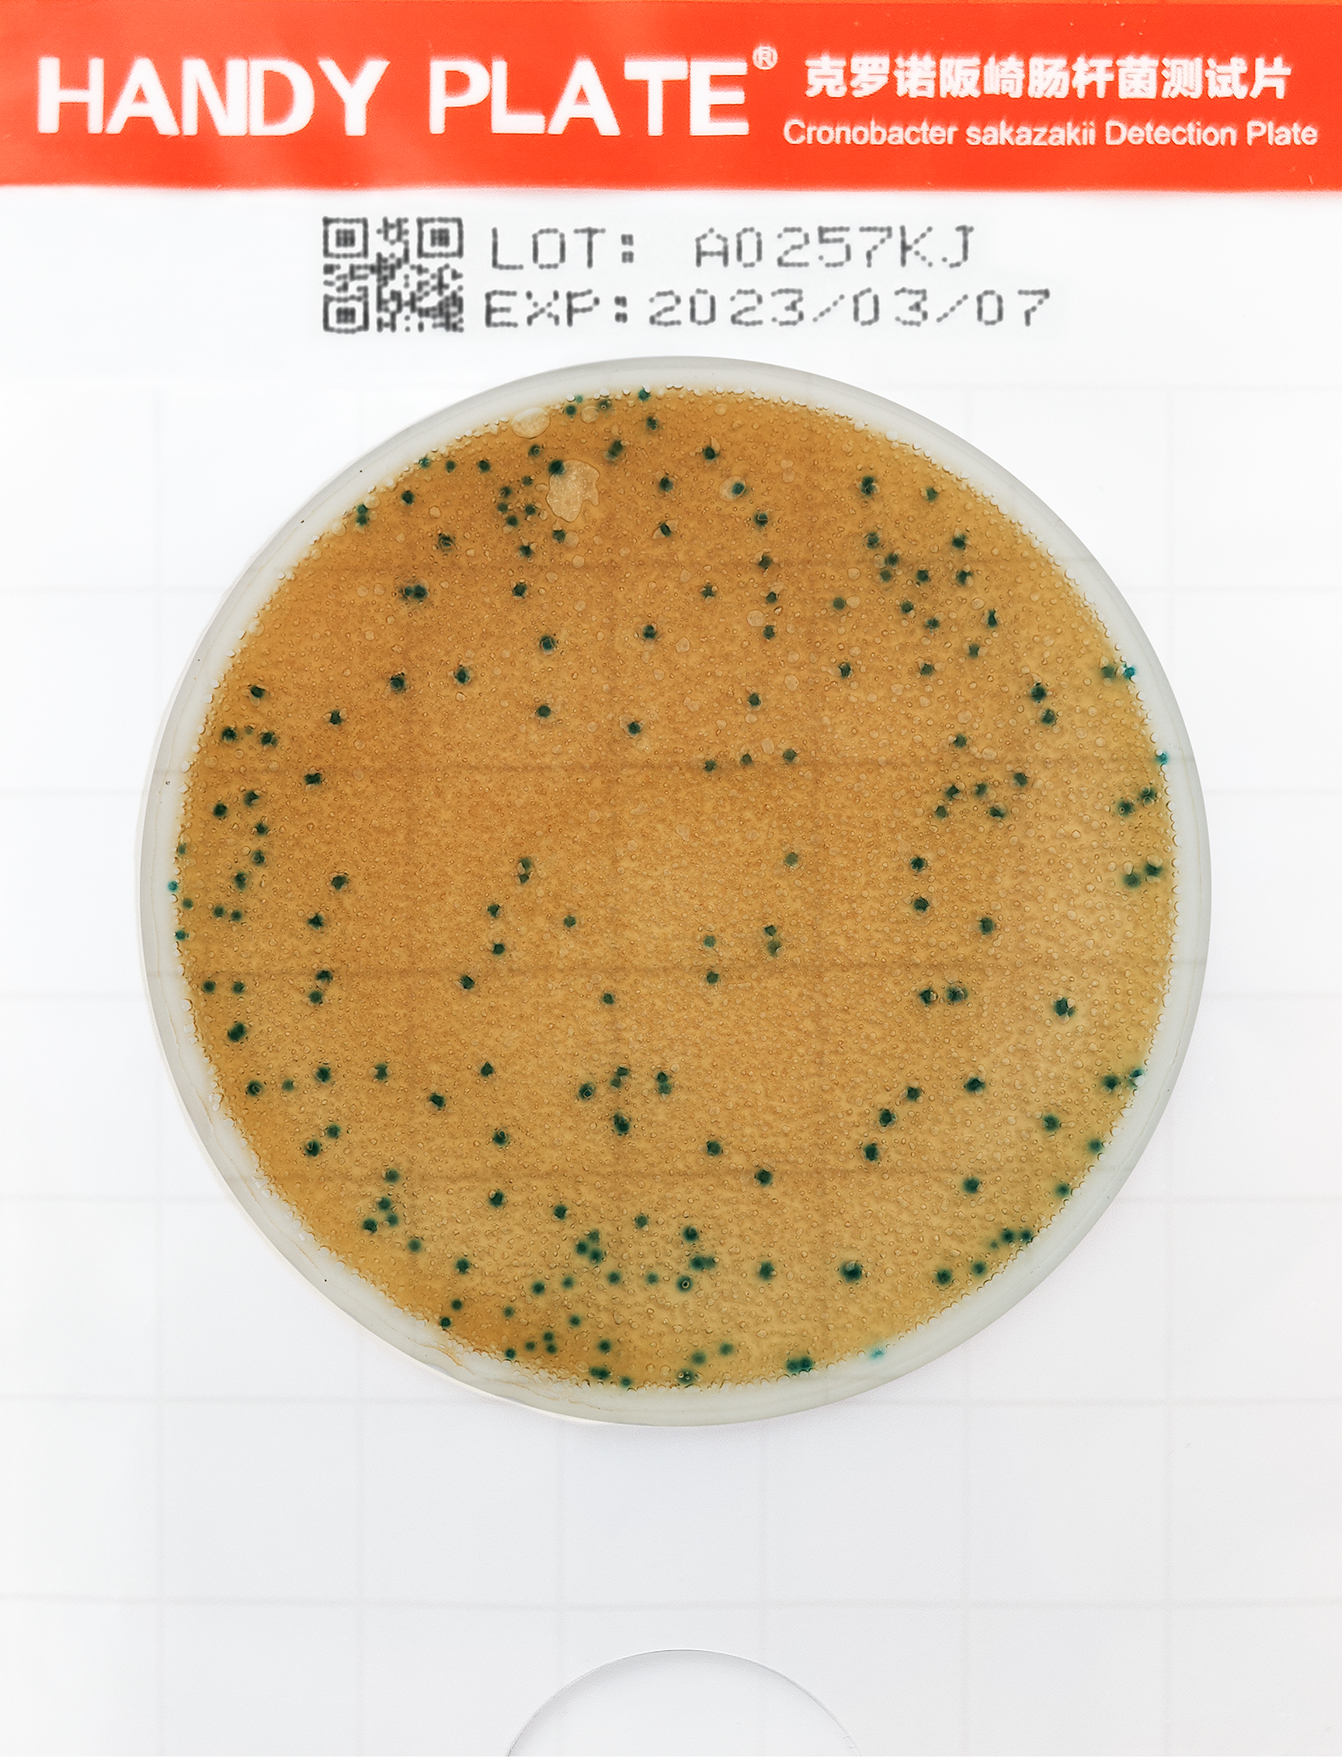
阪崎克罗诺杆菌测试⽚
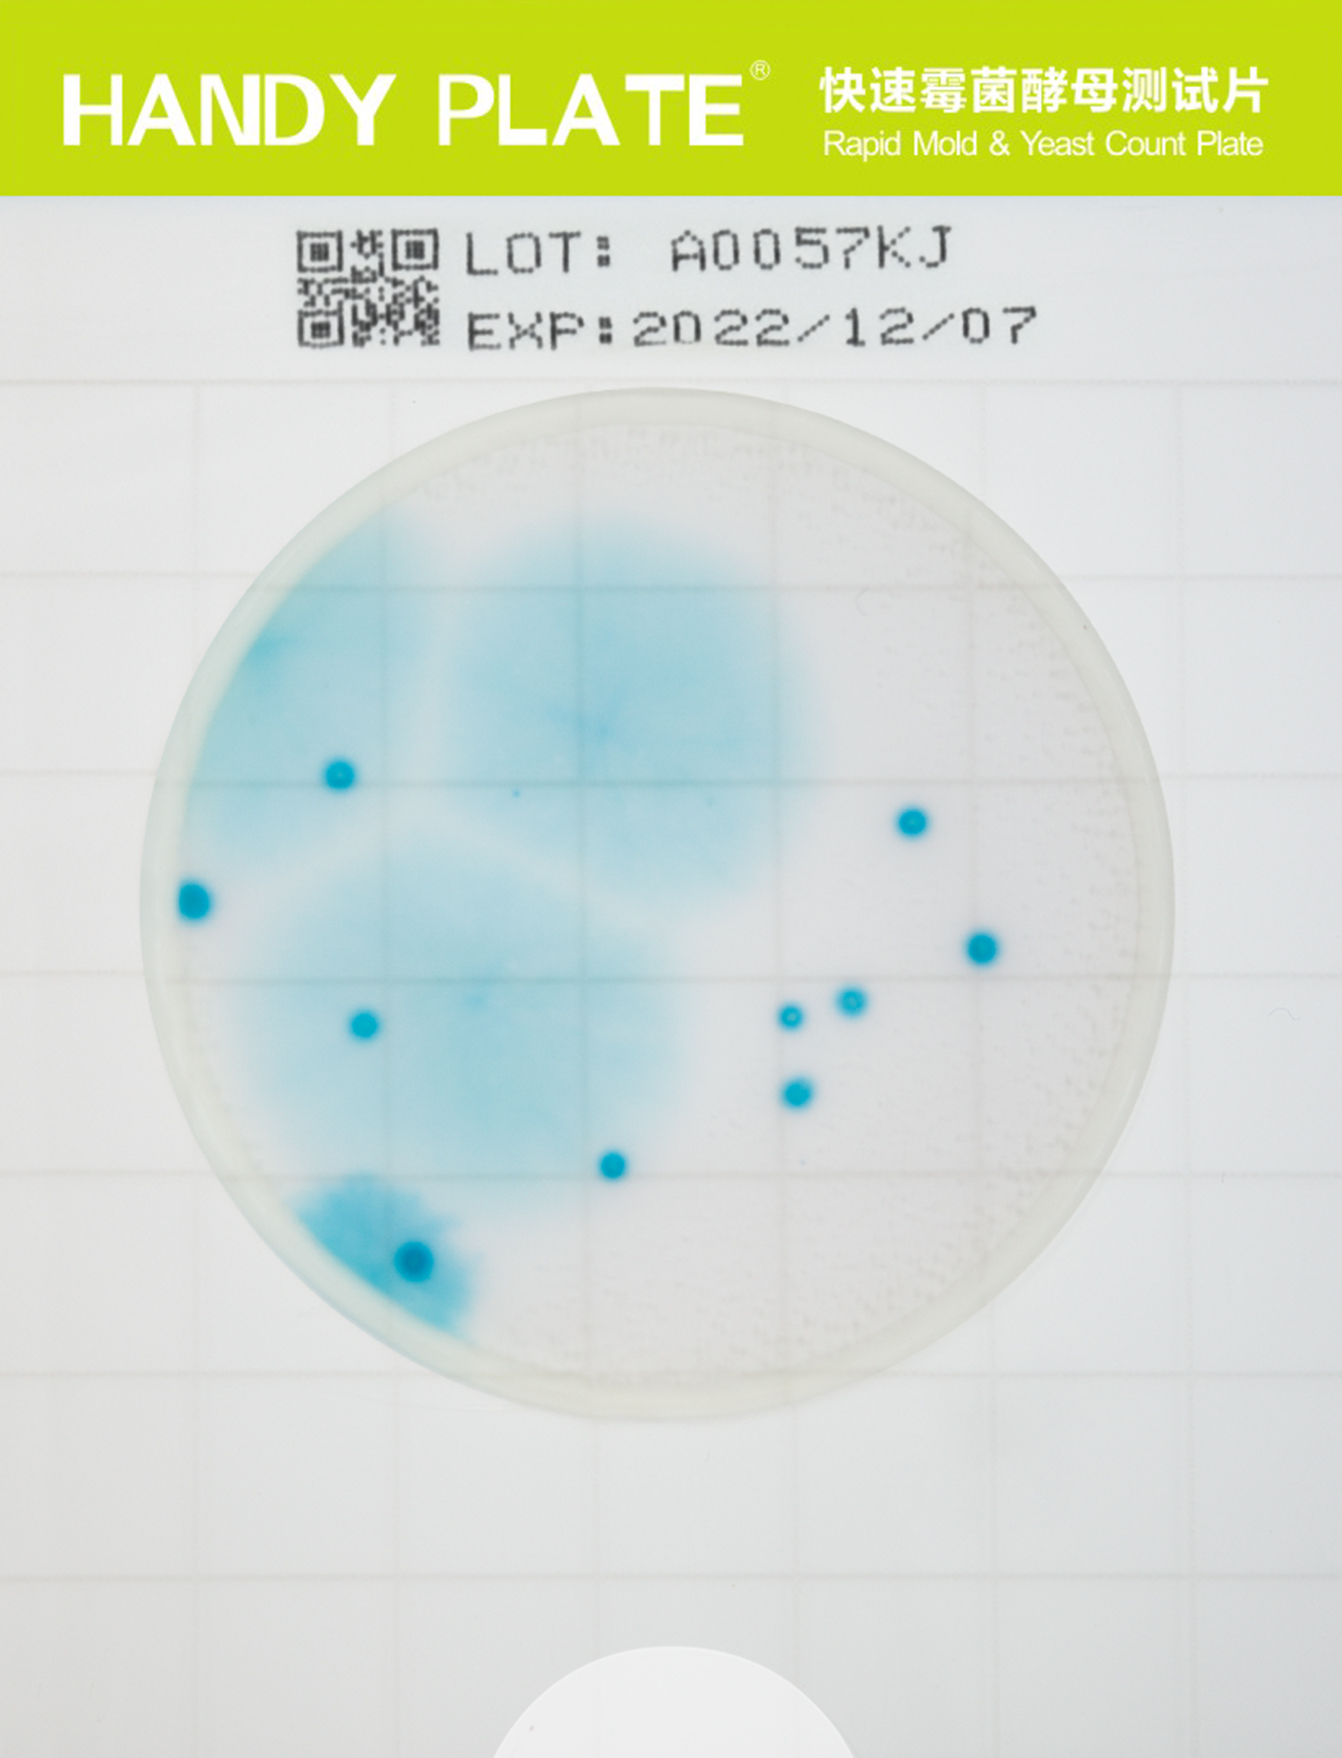
快速霉菌酵⺟测试⽚

相关产品推荐更多 >
万千商家帮你免费找货
0 人在求购买到急需产品
- 详细信息
- 询价记录
- 技术资料
- 库存:
9999
- 英文名:
Handy plate® Mold&Yeast Count Plate
- 保质期:
18个⽉
- 供应商:
广东环凯
- 保存条件:
2~8℃
- 规格:
20片/包
产品名称:霉菌酵母测试片
英文名称:Handy plate® Mold&Yeast Count Plate
产品编号与包装规格:
| 产品编号 | 产品类型 | 包装规格 |
| HP003 | 检测片 | 20 片/包 |
产品用途:用于食品和饮料中霉菌酵母的测定。
产品简介:Handy plate® 霉菌酵母测试片为预制备的即用型培养基产品,含有标准的 培养基、冷水凝胶和显色指示剂。本产品可用于食品和饮料中霉菌酵母的测定。


使用说明:
1,样品制备:取样品 25 g(mL) 放入含有 225 mL 磷酸缓冲液(或生理盐水)的无菌均 质杯或均质袋内,均质器混匀 1 min~2 min 制成 1:10 的样品匀液,必要时用 无菌 1 mol/L NaOH 或 1mol/L HCl 溶液调节样品匀液 pH 至 6.8~7.2。用 1mL 无菌吸管或移液器吸取 1:10 均液 1 mL,注入含有 9 mL 稀释液的试管内,振摇 后成为 1:100 的样品匀液,以此类推制备 10 倍系列稀释的样品匀液,每次换一 支吸管。
2,接种:根据对样品污染状况的估计,选择 2~3 个稀释度进行检测。将霉菌酵母 检测片置于平坦实验台面,揭开上层膜,用无菌吸管吸取 1 mL 样品匀液滴加 到检测片中央,缓缓盖上上层膜,避免产生气泡。静置 3~5min 使样液扩散并 重新形成凝胶。
3,培养:将检测片正面向上水平放置 28℃±1℃,培养 48h~72h。
4,判读:计数所有蓝绿色菌落不论大小和清晰度。合适的计数范围在 15 CFU~150 CFU。淡蓝绿色凸起小菌落为酵母,蓝绿色扁平较大菌落为霉菌。若整个培养 区域呈淡蓝绿色,可能是菌浓度过高,需对样品进一步稀释以获得确切的计数。 如需分离菌落进行进一步分析,揭开上层膜用接种针将菌落挑出使用即可。



(右键“在新标签页中打开图片”可查看高清大图!)
霉菌酵母测试片 检测结果可靠,经验证与国家标准方法拟合度良好
| 纯菌 | 样品(人工污染和自然污染) |
![]() |
![]() |
霉菌酵母测试片判读手册(右键“在新标签页中打开图片”可查看高清大图!)
霉菌酵母测试片为常温常压条件下制备的无菌的一次性产品,含有符合国家标准的培养基、耐液化的凝胶剂和显色指示剂。
按标准要求或说明书推荐培养条件培养后,肉眼或借助放大镜等计数所有红色菌落。菌落数在30~150CFU之间较为适宜。按标准要求或说明书推荐培养条件培养后,肉眼或借助放大镜等计数所有红色菌落。菌落数在30~150CFU之间较为适宜。按标准要求或说明书推荐培养条件培养后,肉眼或借助放大镜等计数所有蓝绿色菌落。菌落数在30-150CFU之间较为适宜。酵母菌为淡蓝绿色小的凸起菌落,霉菌为蓝绿色扁平较大菌落。
使⽤⽅法
只需3步,即可实现快速准确的测定!
![]() |
|||||||||||||||||
|
|
|
|||||||||||||||
|
|
|
|||||||||||||||
|
|
|
|||||||||||||||
风险提示:丁香通仅作为第三方平台,为商家信息发布提供平台空间。用户咨询产品时请注意保护个人信息及财产安全,合理判断,谨慎选购商品,商家和用户对交易行为负责。对于医疗器械类产品,请先查证核实企业经营资质和医疗器械产品注册证情况。
- 作者
- 内容
- 询问日期
技术资料